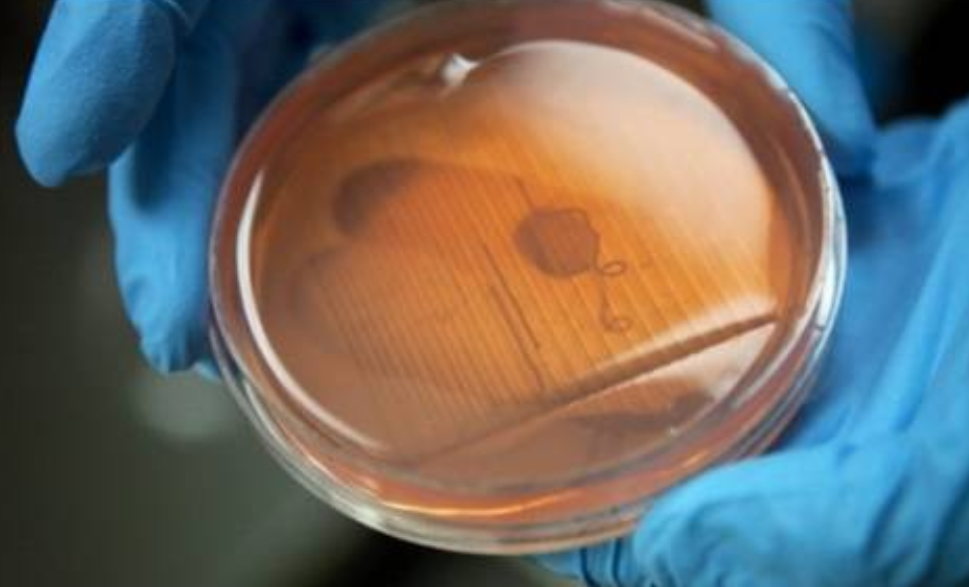

- 价格:电议
- 温度范围:150℃以下
- 电源:380V
- 尺寸:450*350*750
- 冷却介质:水/油
- 工作形式:管线式/在线式
- 主轴转速:14000 rpm
- 料筒形状:管道型
生物墨水实验室在线式超高速均质机,
生物墨水是用于3D生物打印的特殊材料,通过将组织或脏器去除细胞后制成,主要成分包含水凝胶和生物分子。其核心技术在于利用基凝胶作为载体,通过间充质干细胞分化形成组织结构,突破了传统胶原蛋白基墨水的使用限制。在需要再生的组织内注入间充质干细胞,再通过3D打印机制造出与实际器官组织极其相似的人造组织。较以往“生物墨水”制造的组织在细胞分化方面具有较大优势。“生物墨水”通常由水基凝胶或细胞聚集体制成,它们有与细胞兼容的结构。一旦活组织被打印出来,它们就可生长成稳定的结构。
IKN研磨分散机设备参数:
设备等级:化工级、卫生|级、卫生I级、无菌级
电机形式:普通马达、变频调速马达、防爆马达、变频防爆马达、
电源选择:380V/50HZ、220V/60HZ、440V/50HZ
电机选配件: PTC 热保护、降噪型
研磨分散机材质:SUS304、SUS316L、SUS316Ti,氧化锆陶瓷研磨分散机选配:储液罐、排污阀、变频器、电控箱、移动小车研磨分散机表面处理:抛光、耐磨处理
进出口联结形式:法兰、螺口、夹箍
研磨分散机选配容器:本设备适合于各种不同大小的容器
CMD2000研磨机有一定输送能力,对高固含量有一定粘稠度物料,CM2000设计了符合浆液流体特性的特殊转子,进行物料的推动输送所有与物料接触部位均为316L不锈钢,机座采用304不锈钢;特殊要求如:硬度较大物料,对铁杂质要求严苛的物料,管道有一定压力并日需不间断运转的工况,可选磨头喷涂碳化物或陶瓷:CMD2000改良型胶体磨腔体外有夹套设计,可通冷却或者升温介质.
研磨分散机的特点:
1.线速度很高,剪切间隙非常小,当物料经过的时候,形成的摩擦力就比较剧烈,结果就是通常所说的湿磨
2.定转子被制成圆椎形,具有精细度递升的三级锯齿突起和凹槽。
3、定子可以无限制的被调整到所需要的与转子之间的距离
4.在增强的流体湍流下,凹槽在每级都可以改变方向。
5、 高质量的表面抛光和结构材料,可以满足不同行业的多种要求。

生物墨水实验室在线式超高速均质机,新型生物墨水纳米分散机






询价













